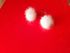

Все разделы
Помпончики норка
3 дня
8 мая в 20:59:38
№ 5032471127Хорошее состояние
0
0
20,00 бел. руб.
7,06$6,03€530,64руб.
Справочно по курсу НБРБ
Физическое лицо
Гомельская область
Гомельская область
Описание лота
| Состояние | Хорошее |
| Сложность | Для всех |
Доставка и оплата
|
|
Возможна пересылка европочтой за счет покупателя
Похожие лоты